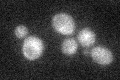
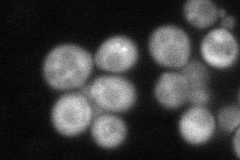
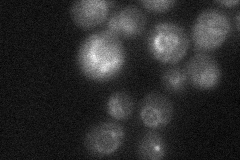
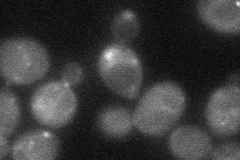
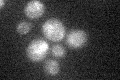

View description
Subunit of TORC1, a rapamycin-sensitive complex involved in growth control that contains Tor1p or Tor2p, Lst8p and Tco89p; contains four HEAT repeats and seven WD-40 repeats; may act as a scaffold protein to couple TOR and its effectors
Localization:
Intensity:
Fold change:
Significance:
-
C’ GFP library in SD
below threshold19.6 -
N' NOP1pr-GFP in SD

cytosol,punctate,vacuole membrane63.1393 -
N' TEF2pr-mCherry in SD
cytosol,punctate67.6218 -
N' NATIVEpr-GFP in SD
ambiguous,vacuole membrane24.0745 -
N' TEF2pr-VC and Cyto-VN in SD
punctate33.0824 -
C’ GFP library in SD+DTT

ambiguous19.520.99No -
C’ GFP library in SD+H2O2

ambiguous22.091.12No -
C’ GFP library in Starvation Media
ambiguous19.580.99No -
C’ GFP library on the background of Pup2-DaMP

below threshold -
C’ GFP library on the background of CCT mutant

below threshold26.25081.3385No
